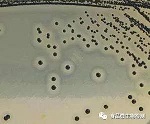
微生物檢驗方法標(biāo)準(zhǔn)解讀之金黃色葡萄球菌

您當(dāng)前的位置:檢測資訊 > 法規(guī)標(biāo)準(zhǔn)
嘉峪檢測網(wǎng) 2021-11-10 21:46
檢驗項目
第一法 金黃色葡萄球菌定性檢驗

01操作步驟
(1)樣品的處理
稱取25g樣品至盛有225mL7.5%氯化鈉肉湯無菌均質(zhì)杯內(nèi),8000r/min~10000r/min均質(zhì)1min~2min,或放入盛有225mL7.5%氯化鈉肉湯無菌均質(zhì)袋中,用拍擊式均質(zhì)器拍打1min~2min。若樣品為液態(tài),吸取25mL樣品至盛有225mL7.5%氯化鈉肉湯的無菌錐形瓶(瓶內(nèi)可預(yù)置適當(dāng)數(shù)量的無菌玻璃珠)中,振蕩混勻。
(2)增菌
將上述樣品勻液于36℃±1℃培養(yǎng)18h~24h。金黃色葡萄球菌在7.5%氯化鈉肉湯中呈混濁生長。
(3)分離
將增菌后的培養(yǎng)物,分別劃線接種到Baird-Parker平板和血平板,血平板36℃±1℃培養(yǎng)18h~24h。Baird-Parker平板36℃±1℃培養(yǎng)24h~48h。
(4)初步鑒定
金黃色葡萄球菌在Baird-Parker平板上呈圓形,表面光滑、凸起、濕潤、菌落直徑為2mm~3mm, 顏色呈灰黑色至黑色,有光澤,常有淺色(非白色)的邊緣,周圍繞以不透明圈(沉淀),其外常有一清晰帶。當(dāng)用接種針觸及菌落時具有黃油樣黏稠感。有時可見到不分解脂肪的菌株,除沒有不透明圈和清晰帶外,其他外觀基本相同。從長期貯存的冷凍或脫水食品中分離的菌落,其黑色常較典型菌落淺些, 且外觀可能較粗糙,質(zhì)地較干燥。
在血平板上,形成菌落較大,圓形、光滑凸起、濕潤、金黃色(有時為白色),菌落周圍可見完全透明溶血圈。挑取上述可疑菌落進(jìn)行革蘭氏染色鏡檢及血漿凝固酶試驗。

(5)確證鑒定
①染色鏡檢:金黃色葡萄球菌為革蘭氏陽性球菌,排列呈葡萄球狀,無芽胞,無莢膜,直徑約為0.5μm~15μm。
②血漿凝固酶試驗:挑取Baird-Parker平板或血平板上至少5個可疑菌落(小于5個全選),分別接種到5mLBHI和營養(yǎng)瓊脂小斜面,36℃±1℃培養(yǎng)18h~24h。
取新鮮配制兔血漿0.5mL,放入小試管中,再加入BHI培養(yǎng)物0.2mL~0.3mL,振蕩搖勻,置36℃±1℃溫箱或水浴箱內(nèi),每半小時觀察一次,觀察6h,如呈現(xiàn)凝固(即將試管傾斜或倒置時,呈現(xiàn) 凝塊)或凝固體積大于原體積的一半,被判定為陽性結(jié)果。同時以血漿凝固酶試驗陽性和陰性葡萄球菌 菌株的肉湯培養(yǎng)物作為對照。也可用商品化的試劑,按說明書操作,進(jìn)行血漿凝固酶試驗。結(jié)果如可疑,挑取營養(yǎng)瓊脂小斜面的菌落到5mLBHI,36℃±1℃培養(yǎng)18h~48h,重復(fù)試驗。
02結(jié)果報告
結(jié)果判定:符合(4)、(5),可判定為金黃色葡萄球菌。
結(jié)果報告:在25g(mL)樣品中檢出或未檢出金黃色葡萄球菌。
03注意要點
(1)7.5%氯化鈉肉湯增菌培養(yǎng):
①若樣品本身在均質(zhì)后清澈,培養(yǎng)18h觀察呈現(xiàn)一定程度的渾濁(與培養(yǎng)前相比),則接種平板;若18h后仍無變化,繼續(xù)培養(yǎng)至24h后無論渾濁與否都接種至平板;
②若樣品本身在均質(zhì)后渾濁,則直接培養(yǎng)至24h后再接種平板。
(2)血平板:36±1℃培養(yǎng)18h后觀察,若有菌落生長或有菌落生長的跡象(無論是否溶血),則應(yīng)酌情配制NA、BHI并分裝至小試管中(NA 10mL/管、BHI 5mL/管)、滅菌后NA應(yīng)斜放凝固成瓊脂斜面?zhèn)溆?。至血平板培養(yǎng)至24h取出,挑取菌落進(jìn)行革蘭氏染色鏡檢,同時挑取菌落接種至NA斜面、BHI肉湯管,36±1℃培養(yǎng)24h。
(3)接種原則:
①革蘭氏染色后還剩余10個或10個以上菌落,則NA、BHI分別接種5管;
②若多于5個(不包括5個)不足10個,則BHI接種5管,剩余的接種NA;
③5個及以下則全部接種BHI,不接種NA。
4.BP平板:
36±1℃培養(yǎng)24h后觀察,有菌落生長則取出,無菌落生長則繼續(xù)培養(yǎng)至48h后再觀察。若血平板已挑取菌落進(jìn)行證實試驗,則不必再挑取BP平板上的菌落進(jìn)行實驗。 若血平板上無菌落生長,則應(yīng)在24h~48h內(nèi)逐步觀察BP平板是否長菌或有無長菌跡象,有則需配置BHI及NA,挑取BP上的菌落進(jìn)行純化、增菌,36±1℃培養(yǎng)24h。
5.血漿凝固酶試驗:
(1)根據(jù)BHI管數(shù),取凍干血漿粉,每瓶用移液槍加入0.5mL生理鹽水,使其充分溶解,再換移液槍槍頭取0.3mLBHI培養(yǎng)物加入其中(每管BHI用1個槍頭),振蕩搖勻后于36±1℃培養(yǎng),計時,每30min觀察一次,如呈現(xiàn)凝固(將試管傾斜或倒置時出現(xiàn)凝塊)或半凝固(一般的液體呈現(xiàn)凝固)則判定為陽性。若一直不凝固,則一直觀察,直至觀察至6h(查看12次)還未凝固,則試驗終止,判定為陰性結(jié)果;若中途出現(xiàn)完全凝固或半凝固,則試驗終止,判定為陽性結(jié)果。
(2)同時取金黃色葡萄球菌標(biāo)準(zhǔn)菌株(ATCC 6538以及CMCC(B)26003各一支)制成菌懸液后作為陽性對照、以滅菌生理鹽水為陰性對照,分別接種至BHI中同步培養(yǎng)后進(jìn)行血漿凝固酶試驗。
(3)若血漿凝固酶試驗結(jié)果可疑,則挑取NA上的菌落接種BHI再次進(jìn)行試驗。
第二法 金黃色葡萄球菌平板計數(shù)法

01操作步驟
(1)樣品的稀釋
①固體和半固體樣品:稱取25g樣品置于盛有225mL 磷酸鹽緩沖液或生理鹽水的無菌均質(zhì)杯內(nèi),8000r/min~10000r/min均質(zhì)1min~2min,或置于盛有225mL稀釋液的無菌均質(zhì)袋中,用拍 擊式均質(zhì)器拍打1min~2min,制成1∶10的樣品勻液。
②液體樣品:以無菌吸管吸取25mL樣品置于盛有225mL磷酸鹽緩沖液或生理鹽水的無菌錐形瓶(瓶內(nèi)預(yù)置適當(dāng)數(shù)量的無菌玻璃珠)中,充分混勻,制成1∶10的樣品勻液。
③用1mL無菌吸管或微量移液器吸取1∶10樣品勻液1mL,沿管壁緩慢注于盛有9mL磷酸鹽緩沖液或生理鹽水的無菌試管中(注意吸管或吸頭尖端不要觸及稀釋液面),振搖試管或換用1支1mL無菌吸管反復(fù)吹打使其混合均勻,制成1∶100的樣品勻液。
④按3操作程序,制備10倍系列稀釋樣品勻液。每遞增稀釋一次,換用1次1mL無菌吸管或吸頭。
(2)樣品的接種
根據(jù)對樣品污染狀況的估計,選擇2個~3個適宜稀釋度的樣品勻液(液體樣品可包括原液),在進(jìn)行10倍遞增稀釋的同時,每個稀釋度分別吸取1mL樣品勻液以0.3mL、0.3mL、0.4mL接種量分別加入三塊Baird-Parker平板,然后用無菌涂布棒涂布整個平板,注意不要觸及平板邊緣。使用前,如Baird-Parker平板表面有水珠,可放在25℃~50℃的培養(yǎng)箱里干燥,直到平板表面的水珠消失。
(3)培養(yǎng)
培養(yǎng)在通常情況下,涂布后,將平板靜置10min,如樣液不易吸收,可將平板放在培養(yǎng)箱36℃±1℃培養(yǎng)1h;等樣品勻液吸收后翻轉(zhuǎn)平板,倒置后于36℃±1℃培養(yǎng)24h~48h。
(4)典型菌落計數(shù)和確認(rèn)
①金黃色葡萄球菌在Baird-Parker平板上呈圓形,表面光滑、凸起、濕潤、菌落直徑為2mm~3mm,顏色呈灰黑色至黑色,有光澤,常有淺色(非白色)的邊緣,周圍繞以不透明圈(沉淀),其外常有一清晰帶。當(dāng)用接種針觸及菌落時具有黃油樣黏稠感。有時可見到不分解脂肪的菌株,除沒有不透明圈 和清晰帶外,其他外觀基本相同。從長期貯存的冷凍或脫水食品中分離的菌落,其黑色常較典型菌落淺些,且外觀可能較粗糙,質(zhì)地較干燥。
②選擇有典型的金黃色葡萄球菌菌落的平板,且同一稀釋度3個平板所有菌落數(shù)合計在20CFU~200CFU之間的平板,計數(shù)典型菌落數(shù)。
③從典型菌落中至少選5個可疑菌落(小于5個全選)進(jìn)行鑒定試驗。分別做染色鏡檢,血漿凝固酶試驗;同時劃線接種到血平板36℃±1℃培養(yǎng)18h~24h后觀察菌落形態(tài),金黃色葡萄球菌 菌落較大,圓形、光滑凸起、濕潤、金黃色(有時為白色),菌落周圍可見完全透明溶血圈。
02結(jié)果計數(shù)
(1)若只有一個稀釋度平板的典型菌落數(shù)在20CFU~200CFU之間,計數(shù)該稀釋度平板上的典型菌落,按式(1)計算。
(2)若最低稀釋度平板的典型菌落數(shù)小于20CFU,計數(shù)該稀釋度平板上的典型菌落,按式(1)計算。
(3)若某一稀釋度平板的典型菌落數(shù)大于200CFU,但下一稀釋度平板上沒有典型菌落,計數(shù)該稀釋度平板上的典型菌落,按式(1)計算。
(4)若某一稀釋度平板的典型菌落數(shù)大于200CFU,而下一稀釋度平板上雖有 典型菌落但不在20CFU~200CFU范圍內(nèi),應(yīng)計數(shù)該稀釋度平板上的典型菌落,按式(1)計算。
(5)若2個連續(xù)稀釋度的平板典型菌落數(shù)均在20CFU~200CFU之間,按式(2)計算。
計算公式


03結(jié)果報告
根據(jù)上面的公式計算結(jié)果,報告每g(mL)樣品中金黃色葡萄球菌數(shù),以CFU/g(mL)表示;如T值為0,則以小于1乘以最低稀釋倍數(shù)報告。
04注意要點
(1)取1mL樣品稀釋勻液接種3個BP平板(此處并未嚴(yán)格按照標(biāo)準(zhǔn)中0.3mL、0.3mL、0.4mL精確取樣,由于如此操作會增加試驗時間,無法在15min內(nèi)完成試驗)。
(2)涂布時不要觸及平板邊緣(會導(dǎo)致樣液涂抹不均勻,大部分匯集于邊緣)。
(3)可用同一根涂布棒從低稀釋度到高稀釋度進(jìn)行涂布(不用換涂布棒)。
(4)涂布完成后應(yīng)稍微放置一段時間使培養(yǎng)基吸收樣品勻液。
(5)若水珠較多,可正置于培養(yǎng)箱中1~2h后再倒置培養(yǎng)。
(6)36±1℃培養(yǎng)24h后觀察,有典型菌落生長則進(jìn)行證實試驗(革蘭氏染色鏡檢、血漿凝固酶試驗、劃線血平板)。若無菌落生長則繼續(xù)培養(yǎng)至48h后再觀察,有典型菌落生長則進(jìn)行證實試驗,無典型菌落生長則試驗終止。
第三法 金黃色葡萄球菌MPN計數(shù)法

01操作步驟
同第二法
02接種培養(yǎng)
(1)根據(jù)對樣品污染狀況的估計,選擇3個適宜稀釋度的樣品勻液(液體樣品可包括原液),在進(jìn)行10倍遞增稀釋的同時,每個稀釋度分別接種1mL樣品勻液至7.5%氯化鈉肉湯管(如接種量超過1mL,則用雙料7.5%氯化鈉肉湯),每個稀釋度接種3管,將上述接種物36℃±1℃培養(yǎng),18h~24h。
(2)用接種環(huán)從培養(yǎng)后的7.5%氯化鈉肉湯管中分別取培養(yǎng)物1環(huán),移種于Baird-Parker平板36℃±1℃培養(yǎng),24h~48h。
03典型菌落確認(rèn)
同第二法
04結(jié)果報告
根據(jù)證實為金黃色葡萄球菌陽性的試管管數(shù),查MPN檢索表,報告每g(mL)樣品中金黃色葡萄球菌的最可能數(shù),以MPN/g(mL)表示。
05注意要點
(1)樣品稀釋同菌落總數(shù),取3個連續(xù)稀釋度稀釋液(或包括液體樣品原液),每個稀釋度接種3管7.5%氯化鈉肉湯,每管接種1mL,36±1℃培養(yǎng)18h后觀察,若出現(xiàn)渾濁則接種至BP平板,若無變化則繼續(xù)培養(yǎng)至24h后再接種至BP平板。
(2)劃線接種至BP平板,36±1℃培養(yǎng)24h后觀察,有典型菌落生長則進(jìn)行證實試驗(革蘭氏染色鏡檢、血漿凝固酶試驗、劃線血平板)。若無菌落生長則繼續(xù)培養(yǎng)至48h后再觀察,有典型菌落生長則進(jìn)行證實試驗,無典型菌落生長則試驗終止。
(3)根據(jù)證實后的陽性管數(shù)差MPN表得出結(jié)果。

來源:Internet